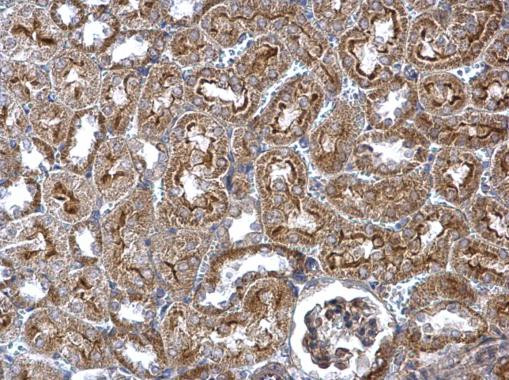
WNT4 Antibody in Immunohistochemistry (Paraffin) (IHC (P))

Search
Invitrogen
WNT4 Polyclonal Antibody
{{$productOrderCtrl.translations['antibody.pdp.commerceCard.promotion.promotions']}}
{{$productOrderCtrl.translations['antibody.pdp.commerceCard.promotion.viewpromo']}}
{{$productOrderCtrl.translations['antibody.pdp.commerceCard.promotion.promocode']}}: {{promo.promoCode}} {{promo.promoTitle}} {{promo.promoDescription}}. {{$productOrderCtrl.translations['antibody.pdp.commerceCard.promotion.learnmore']}}
产品信息
PA5-27321
已发表种属
宿主/亚型
分类
类型
抗原
偶联物
形式
浓度
规格
保存条件
运输条件
RRID
产品详细信息
Recommended positive controls: 293T, HepG2, WNT4 transfected 293T lysate, V5-human Wnt4-transfected 293T.
Predicted reactivity: Mouse (100%), Rat (99%), Japanese Medaka (84%), Xenopus laevis (90%), Chicken (89%).
Store product as a concentrated solution. Centrifuge briefly prior to opening the vial.
靶标信息
The WNT gene family consists of structurally related genes which encode secreted signaling proteins. These proteins have been implicated in oncogenesis and in several developmental processes, including regulation of cell fate and patterning during embryogenesis. This gene is a member of the WNT gene family, and is the first signaling molecule shown to influence the sex-determination cascade. It encodes a protein which shows 98% amino acid identity to the Wnt4 protein of mouse and rat. This gene and a nuclear receptor known to antagonize the testis-determining factor play a concerted role in both the control of female development and the prevention of testes formation. This gene and another two family members, WNT2 and WNT7B, may be associated with abnormal proliferation in breast tissue. Mutations in this gene can result in Rokitansky-Kuster-Hauser syndrome and in SERKAL syndrome.
⚠WARNING: This product can expose you to chemicals including mercury, which is known to the State of California to cause birth defects or other reproductive harm. For more information go to www.P65Warnings.ca.gov.
仅用于科研。不用于诊断过程。未经明确授权不得转售。